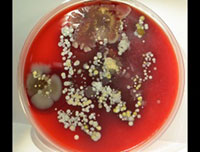
Mortality

Below are the May Medical Staff Updates. As a reminder, all providers must complete the attestation at the bottom of this page by May 31.
Medical Leadership Message
 We all know the old joke, “April showers bring Mayflowers. What do Mayflowers bring? Pilgrims!” It’s a pretty funny joke when you are in the third grade. Of course, Mayflower is also the name of a moving company. So what do Mayflowers bring? Change!
We all know the old joke, “April showers bring Mayflowers. What do Mayflowers bring? Pilgrims!” It’s a pretty funny joke when you are in the third grade. Of course, Mayflower is also the name of a moving company. So what do Mayflowers bring? Change!
We are seeing plenty of change around Kaleida Health these days, especially as we continued to march towards the completion and successful move of the Oishei Children’s Hospital. It is truly an exciting time, and everyone is looking forward to helping with the process. Yet there continues to be more going on across all of Kaleida Health. Change is everywhere.
The areas of quality and patient safety remain Kaleida Health’s top priority. Change is evident in the roll out of some new programs addressing sepsis, hospital acquired infections and conditions and the patient experience. There is now a greater emphasis on department medical directors taking leadership roles in these endeavors. There is always room for more physician leadership. Please contact your medical director or chief medical officer to see how you can become involved in these changing times.
Kaleida Health is also working towards improved physician communication. A new ”Physician Communication Tool” was rolled out to all of the chief medical officers and chiefs of service in order to improve how we communicate with the medical staff that we serve. The hope is that we will be able to provide more “directed” emails in an effort to reduce some of the “clutter” that is generated in your emails. We will be looking for feedback on these emails as well as any other methods of communication you feel will work best for Kaleida Health’s medical staff.
Change is a good thing and is not something to be feared. As physician leaders, it is our responsibility to be the driving force behind change. We should and are the ones who are steering the change in order to improve health care throughout Kaleida Health. Thank you to all those who helped us develop these changes and to those who will continue the efforts to make positive changes at Kaleida Health. Enjoy the spring – summer will be here shortly!
David Hughes, MD, MPH
Chief Medical Officer
Kaleida Health
Kenneth Snyder, MD, PhD
Vice President, Physician Quality
Kaleida Health
Colin McMahon, MD
Chief Medical Officer
Buffalo General Medical Center/Gates Vascular Institute
David Pierce, MD, FACEP
Chief Medical Officer
Millard Fillmore Suburban Hospital and DeGraff Memorial Hospital
Stephen Turkovich, MD
Chief Medical Officer
Women & Children’s Hospital of Buffalo
Message from the President of the Medical/Dental Staff
 On April 27, we had the first-ever joint Medical/Dental Staff meeting for Kaleida Health and ECMC. This historic event represents a dramatic change in the relationship between the organizations from a decade ago. With the University at Buffalo, the formation of Great Lakes Health began a transformation in how we provide health care to our community, moving us into partnership around the goal of improving the health and growth of our community, the nation and the world.
On April 27, we had the first-ever joint Medical/Dental Staff meeting for Kaleida Health and ECMC. This historic event represents a dramatic change in the relationship between the organizations from a decade ago. With the University at Buffalo, the formation of Great Lakes Health began a transformation in how we provide health care to our community, moving us into partnership around the goal of improving the health and growth of our community, the nation and the world.
The strength of this partnership could not have been better illustrated than in the response to the attack on ECMC’s computer systems. Although ECMC was the target, all of the partners were affected and all of the partners responded. I particularly want to thank Cletis Earle, Kaleida Health’s chief information officer, J. Brice Bible, University at Buffalo’s chief information officer, and Ray Dannenhoffer, the director of the Office of Medical Computing, for their rapid response to the event and offers of help to ECMC.
We learned that an attack on one is an attack on all. We learned that we are intertwined, interconnected and integrated. We learned that complete health care for the community cannot be provided without all partners fully functioning. We learned that we all, physicians, institutions and patients, succeed together or fail together.
As we enter an era of uncertainty in healthcare funding, we must stay focused on our key goals: excellent healthcare and access for all. I believe we must stand up for quality; I believe we must stand up for access. I ask you to work with me, I ask you to speak out with me, and I ask you to believe with me.
Peter Winkelstein, MD, MS, MBA, FAAP
Medical/Dental Staff President
Kaleida Health
Quality Update
 click to enlarge
click to enlargeHospital Acquired Infections
All of Kaleida Health’s top five Hospital Acquired Infections (HAI) – CAUTI, CLABSI, Colon SSI, C. diff, and MRSA – improved from the previous year, two of which are statistically significantly better.
Readmissions
As we shared last month, Kaleida Health is the only local hospital that did not receive a penalty for Fiscal Year (FY) 2017. The FY2017 readmission results reflect performance from July 1, 2012-June 30, 2015.
 click to enlarge
click to enlarge
Kaleida Health is seeing readmissions trending up, expecting a penalty for FY2018, which reflects performance from July 1, 2013-June 30, 2016.
Mortality Rates Impacting Value Based Payment
 click to enlarge
click to enlargeMortality rates in the three primary diagnosis categories of acute myocardial infarction (AMI), heart failure and pneumonia have all decreased in the past few years. The incorporation of evidence-based medicine has greatly contributed to the mortality reduction, as well as multidisciplinary rounds and rapid response teams. Kaleida Health is currently evaluating palliative care services to improve the quality of life and care of adults with serious illness.
Finance Update
Kaleida Health’s first quarter operating income of $7.3 million is in line with the budgeted plan, an increase of $2 million over the first quarter of 2016.
These successful results are driven by:
• Improved efficiency (cost per case)
• Home Care volume growth
• Growth at Buffalo General Medical Center
• Increase in outpatient visits
• Increased severity of cases
Kaleida Health continues to implement our business development initiatives and affiliation plans (MASH, Western New York Urology/Cancer Care of WNY, Southern Tier hospitals, etc.). In addition, the organization is enhancing its nurse staffing levels. More than 150 nurses have been hired since January 2016.
Monthly Webinar: Oishei Children’s Hospital Move Update
This month's webinar features Cassie Church, RNC, MSN, NEA-BC, clinical project move manager, Women & Children’s Hospital of Buffalo, discussing what a safe move will look like this fall from Women & Children’s Hospital of Buffalo to the new John R. Oishei Children’s Hospital. For questions, please email cchurch@kaleidahealth.org or call 716-878-7495.
Click HERE to watch the webinar.What’s On Your Hands?
Henry Ford Health System in Detroit, Michigan, conducted a hand-hygiene study and captured images of bacteria and other growth found on items such as doorknobs, nurse station mouse/keyboard, healthcare workers' hands, mobile phones and unused gloves. If you cross the plane of the door, regardless if you touch anything, you must perform hand hygiene (think “gel in, gel out”). The Purell hand hygiene product is now available in more convenient locations to improve use. If you are approached by a care team member to wash your hands, say "thank you" and perform hand hygiene.
Research as a Catalyst for Development of the BNMC
The partnership between research, scholarship and clinical care continues to grow on the Buffalo Niagara Medical Campus (BNMC) as evidenced by the latest completed project directed by Andrew H. Talal, MD, MPH, professor of medicine at the University at Buffalo.
While the research project is novel, innovative and addresses important scientific knowledge gaps, the major attestation of the study is leverage of diverse segments of the BNMC into a harmonious alliance to produce highly significant research outcomes. In this situation, research is a catalyst to engage all aspects of a modern academic health center. As stated by Dr. Talal, “This is truly work that represents the collaboration of all segments of an academic health center. Patients were initially evaluated in the Clinical and Translational Research Center, liver sampling was performed in the radiology suite at Buffalo General Medical Center, HCV RNA levels were measured in Kaleida Health’s Flint Road facility, and drug concentrations were measured at the UB Translational Pharmacology Research Core. Flow Cytometry was performed at Roswell Park Cancer Institute (RPCI).”
The project entitled, “Hepatic Pharmacokinetics and Pharmacodynamics with Ombitasvir/Paritaprevir/Ritonavir Plus Dasabuvir Treatment and Variable Ribavirin Dosage” was sponsored by AbbVie and was conducted at two sites: the BNMC and the University of Paris-Est in France. The primary objective of the study was to evaluate and to compare the decline of hepatitis c virus (HCV) RNA in plasma and liver of patients on varying ribavirin dosages. A second study objective was to compare, for the first time, liver-to-plasma direct acting antiviral (DAA) drug concentration ratios. Liver tissue samples were obtained via liver fine needle aspiration (FNA), which is a relatively new liver sampling method that Dr. Talal pioneered and has further refined.
For the first time in patients treated with an all-oral, direct acting antiviral regimen, researchers found that the virus decay in plasma was more rapid than in liver tissue. This is also the first study to collect human liver tissue for the pharmacokinetic analysis of an all-oral regimen for hepatitis C. It demonstrates that the technique of liver sampling by fine needle aspiration could be highly beneficial for future studies of pharmacokinetics and pharmacodynamics within liver tissue. It also offers a potential mechanism to explore how liver disease affects drug metabolism.
Dr. Talal presented the findings of the study on April 20 at the European Association for the Study of Liver Disease (EASL) annual International Liver Congress. Special thanks to Dr. Gene Morse, SUNY Distinguished Professor, who directs the CTSI Drug Development Core and the UB Center for Integrated Global Biomedical Sciences, Dr. John Tomaszewski, professor and chairman of UB’s Department of Pathology and Anatomical Sciences, and Chief of Laboratory Services at Kaleida Health who directs the Flint Road laboratory facility where HCV RNA levels were measured, and Dr. Paul Wallace, director of RPCI Flow Cytometry faculty.
Medical Staff Attestation - May 2017
By submitting this attestation, I confirm that as a member of the medical staff I have read and understand the information included in this email from Kaleida Health in accordance with Kaleida Health policy MED.41 as approved by the Medical Executive Committee.
| Fields marked with an asterisk (*) are required. |
|
|